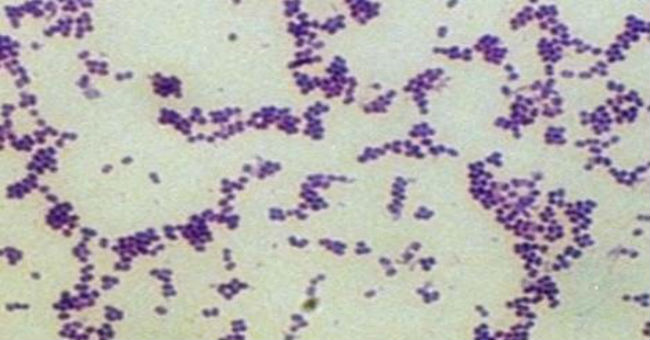
菌

綠豆的神奇之處
“肚子一空,萬事皆空”,飲食早已不再局限於解決溫飽那麼簡單了,
吃什麼,怎麼吃,如何揚長避短髮揮其最佳功效越來越受到重視。
夏季飲湯,以冰鎮綠豆湯最為普及,其消暑益氣、清熱解毒、潤喉止渴的功效廣為傳頌。
但事實上,綠豆,遠不止那麼簡單!
一、綠豆:濟世之良谷
綠豆,性涼味甘,歸心、胃經,其營養價值豐富,用途廣泛,是人們餐桌上常見的美食。
1.清熱解毒
綠豆中的蛋白質、鞣質和黃酮類化合物可與有機磷、重金屬等。
結合成沉澱物,降低甚至消除毒性,且不易被胃腸道消化吸收,有解毒功效。也可配合清熱解毒的中藥提高療效。

2.消暑解暑
高溫時大量出汗,機體的營養成分快速丟失,會引起內環境紊亂。
而綠豆性涼,富含無機鹽、維生素等營養成分,高溫環境下的綠豆湯有助於及時補充營養,達到清熱解暑的功效。

3.抗菌抑菌
綠豆富含多種生物活性物質,如:單寧、黃酮類化合物、植物甾醇等。
可提高免疫力,增強對葡萄球菌等細菌的抑製作用,達到抗菌抑菌的功效。
4.降低心腦血管疾病風險
綠豆中的植物甾醇、多醣等成分能減少腸道對膽固醇的吸收,
促進膽固醇在肝臟中的分解,從而降低血清膽固醇、血脂等,減少心腦血管疾病風險。

二、巧用綠豆、養生功效奇
綠豆,藥食同源,除了常見的綠豆湯,還有哪些用法?
1.綠豆湯
大火熬煮綠豆,待開鍋後迅速將剝裂出的豆皮撈出,為綠豆衣,清熱解毒效果最好,但口感稍差;
而煮爛的綠豆已經不具備清熱的藥性,而是作為食物的營養價值更好,因此多喝綠豆粥有滋補五臟尤其是肝臟的作用。

● 清熱解暑綠豆湯
● 烹調步驟
★皮膚不清爽需長痘
★美容皮面不均,是五臟六腑,出現形成表徵,表現出來的,必自我健康知識。 月經證各種表現是警訊 閉經、痛經、停經、子宮出血、更年期、躁鬱症,是身體的警訊,您必自我了解知識修護。您立即必需知的知識。 腰酸背痛是身體的警訊 您必自我了解知識修護。您立即必知的知識。 血壓高低者是警訊 是身體出現者,必自我先知,防病變未來知識。您立即必知的知識。 什麼是溫熱體 濕熱毒是重病源的。您立即必需知的知識。是保健康,保命長壽的守則。 蹲下去站不起來 起來很困難,是氣沒了,血沒了。您立即必知的知識。 氣虛血虛的 是身體的警訊,您必自我了解知識修護。您立即必知的知識。 憂鬱症是疾病原 您必自我了解知識修護。 過敏性是身體的風證過高 過敏體質是健康退化的表徵
您立即必知的知識。
健康需知保健
- 婦女證狀,學習會員知識須知,健康美麗。
- 四季感冒、八種咳嗽,學習會員知識防感染。
(一般感冒有五種證型,咳嗽有八種證型,需學習知識防感染。)

① 綠豆清洗乾淨後放進冰箱冷凍片刻,再放入鍋內;
② 鍋中加入清水,以沒過綠豆2-3cm為宜,大火煮開後改中火煮10分鐘左右,並不停攪拌;
③ 綠豆煮至開花後,可添加適量清水,再用大火煮開,用勺子撇去浮沫,加入適量冰糖即可。
● 注意事項
① 烹煮時間不宜過長
桑拿天裡常喝的綠豆湯,時間不宜過長,最好是綠豆熬煮半小時內的湯汁,不僅清熱解暑的效果更好,其口感也更佳。
② 忌用鐵鍋煮
綠豆的單寧在高溫時遇鐵會生成黑色的單寧鐵,綠豆湯汁會變黑並產生特殊氣味,不但影響食慾、味道,而且有害人體健康。

2.綠豆芽
綠豆發成綠豆芽後,營養價值更高。
如大分子物質分解成小的活性成分,形成並不斷累積很多不同種類的活性物質,如多酚、維生素C等,常吃可增強免疫力。
但芽苗類蔬菜,容易滋生大腸桿菌。
發芽過程中出現水污染,大腸桿菌會沾在葉子上,生吃時容易帶入體內,建議高溫烹調食用。

3.綠豆蠶砂枕
具有清熱明目、安神、清肝的作用,適宜愛上火、頭疼、陰虛陽亢的人群。
蕎麥皮、綠豆、蠶砂、決明子,按1:1:1:1的比例裝入枕套中,也可以加入具有疏肝作用的合歡花10-20g,但受風寒頭痛者慎用綠豆蠶砂枕。

三、綠豆雖好,也有禁忌
綠豆,被稱為食物中的“鍾馗”,但有些人群不宜過多食用。
1.體質寒涼人群
寒涼體質的人群,一般已有四肢冰涼、全身乏力、腰腿冷痛、腹瀉便稀等症狀。
綠豆性涼,反而寒上加寒,加重症狀,易引發腹瀉等消化系統疾病。

2.體質虛弱人群
綠豆,富含膳食纖維及高蛋白質,但體質偏弱人群,往往伴有腸胃功能較差的症狀,綠豆吃得過多,容易引起消化不良,出現腹瀉等症狀。
對於部分喝綠豆湯後容易打嗝甚至反酸的人群,更不建議食用。

3.經期症狀明顯的女性
月經期有很多女性有小腹痛、腰骶部下墜及痛經等症狀表現,一般為氣血不足、體質偏寒的表現。
平時過多飲用冰鎮綠豆湯及在經期過多飲用偏寒的綠豆湯,會誘發或加重經期的不適感。

4.服用溫補藥物的人群
中醫的組方通常由多味藥物組合而成,也講究藥食同源,綠豆清熱解毒,也是一味中藥。
與溫補藥物同食易發生反應,降低藥效。最好服用藥物後2小時左右再食用綠豆製品。

冰鎮綠豆湯雖能迅速降溫,但心腦血管疾病患者不宜食用過多,尤其是在全身出汗時,可能誘發心肌梗死、腦血栓或腦出血等急症。
物理調理美容應用
營養食物知識傳播
全民健康知識傳播保健團體,
讓更多人了解健康,增加養生的知識。
加入全民學習會員聯盟知識健康、營養師、藥師、醫師、免費諮詢、調理健康福利

文章圖片等部分內容及素材,來源於互聯網及其他公眾平台,中醫師、藥師、醫生、營養師,"由於文字、圖片、漫畫整理編輯發佈",主要目的分享信息,供全民健康知識傳播,如果文字、圖片或轉載內容涉及版權問題,請原作者及時告知,我們將立即更改或刪除。







 晚飯十種寶,一生身體好
晚飯十種寶,一生身體好  聰明吃豆腐,省錢又滋補
聰明吃豆腐,省錢又滋補  枇杷這樣吃,降火又養顏
枇杷這樣吃,降火又養顏  多吃發酵葡萄好處多
多吃發酵葡萄好處多  炒大米,健康排毒顧脾胃!
炒大米,健康排毒顧脾胃!  十大抗癌食物排行榜!
十大抗癌食物排行榜!  枇杷葉煮水,抗癌又好喝
枇杷葉煮水,抗癌又好喝  夏季第一瓜—冬瓜
夏季第一瓜—冬瓜